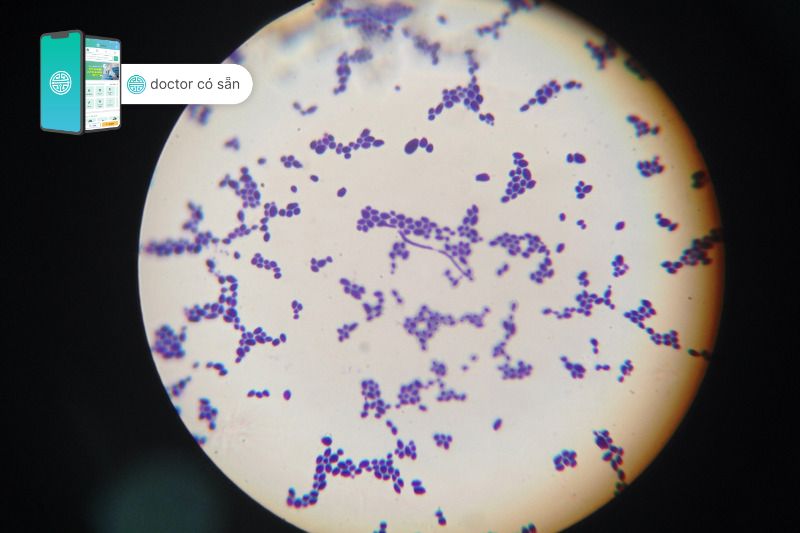

Ngứa tai trái, phải là một triệu chứng điển hình của viêm tai ngoài, một bệnh lý cấp tính có thể xuất hiện ở mọi lứa tuổi. Những vấn đề về tai này thường xuất hiện nhiều vào các tháng hè, nguyên nhân có thể do bơi lội, các bệnh về da liễu tăng trong thời tiết nắng nóng, độ ẩm cao. Do đó, cần có những hiểu biết cơ bản về triệu chứng ngứa tai trái và các biện pháp bảo vệ tai để có thể ngăn chặn những trường hợp nhiễm trùng nặng. Doctor có sẵn sẽ cung cấp cho bạn những thông tin hữu ích về ngứa tai ở bài viết này.
Tóm tắt nội dung
- 1 1. Nguyên nhân gây ngứa lỗ tai trái
- 2 2. Ngứa tai trái báo hiệu bệnh gì
- 3 3. Một vài chẩn đoán liên quan đến ngứa lỗ tai trái
- 4 4. Điều trị ngứa lỗ tai trái
- 5 5. Biện pháp phòng ngừa ngứa tai trái
- 6 6. Lưu ý khi bị ngứa vành tai trái
- 7 7. Khi nào cần đi khám và điều trị ngứa tai trái?
- 8 8. Câu hỏi thường gặp
1. Nguyên nhân gây ngứa lỗ tai trái
Có rất nhiều nguyên nhân gây ngứa lỗ tai mà hầu như mọi đối tượng vẫn thường xuyên gặp phải, một số nguyên nhân cụ thể có thể kể đến như sau:
- Bơi lội hoặc để tai tiếp xúc với nước quá lâu làm mất cân bằng độ ẩm da.
- Vệ sinh tai quá mức, gãi tai quá mạnh.
- Các thiết bị trợ thính, tai nghe, mũ trùm tai có thể gây bí bách và dẫn đến sự phát triển của vi khuẩn làm ngứa lỗ tai và có thể ngứa cả vành tai.
- Dị ứng các chế phẩm như: dầu gội đầu, tăm bông, mỹ phẩm,…
- Bệnh lý về da liễu như: viêm da tiếp xúc, vẩy nến,…
- Chấn thương tai trong một số tình huống cũng dẫn đến ngứa tai trái do ảnh hưởng đến quá trình sản xuất ráy tai và các tế bào biểu mô.
2. Ngứa tai trái báo hiệu bệnh gì
Ngứa tai trái hay ngứa tai phải có thể là báo hiệu tình trạng tai của bạn đang gặp vấn đề. Trước tiên, nếu có tình trạng ngứa tai trái, hãy kiểm tra kỹ vành tai trái và cả tai phải của bạn. Trong trường hợp có ban đỏ, sưng đau kèm ngứa có thể tai của bạn đã bị viêm và cần đến khám tại các cơ sở y tế để được điều trị kịp thời.
Trong trường hợp đã không xác định được nguyên nhân hoặc không có sự xuất hiện các triệu chứng khác ngoài ngứa (ví dụ: sưng đỏ vành tai, đau, rỉ dịch, ù tai, ngứa gây khó chịu,…), bạn có thể theo dõi triệu chứng ngứa. Nếu tình trạng ngứa càng ngày càng nặng và ảnh hưởng đến sinh hoạt thường ngày, bạn nên đi khám bác sĩ để được tư vấn và tìm nguyên nhân.
Xem thêm: Tai bị ù 1 bên: Một số kiến thức mà bạn không nên bỏ qua
3. Một vài chẩn đoán liên quan đến ngứa lỗ tai trái
3.1. Viêm tai ngoài
Viêm tai ngoài có thể xảy ra ở mọi lứa tuổi, tuy nhiên tỉ lệ cao ở trẻ em dưới 9 tuổi và giảm dần theo độ tuổi. Khi tiếp xúc với nước quá lâu sẽ phá vỡ hàng rào bảo vệ da-ráy tai dẫn đến viêm và phù nề gây ngứa. Gãi tai do ngứa có thể gây tổn thương tai và làm trầm trọng thêm tình trạng viêm dẫn đến nhiễm trùng nếu không được chăm sóc đúng cách.
3.2. Bệnh nấm tai
Nấm tai có thể là hậu quả của nhiễm trùng ống tai do sử dụng kháng sinh hoặc có thể diễn ra song song với quá trình viêm tai.
Aspergillus niger và Candida là nguyên nhân chính gây nấm tai, thường xuất hiện ở các khu vực nhiệt đới, cận nhiệt đới ẩm.
Ngứa tai trái, có/không có tiết dịch, cảm giác khó chịu ở tai là những triệu chứng thường gặp khi bị nấm tai.
3.3. Bệnh vẩy nến
Vẩy nến thường liên quan đến ống tai ngoài, gây mẩn đỏ kèm ngứa, đóng vẩy lan đến vành tai và mang tai.
3.4. Viêm da tiếp xúc
Viêm da tiếp xúc thường được nghĩ đến trong trường hợp không có yếu tố nguy cơ của viêm tai ngoài hay nhiễm trùng, nhiễm nấm tai. Ngứa là triệu chứng nổi trội, ban đỏ lan rộng đến vùng da tiếp xúc với hóa chất dị ứng, có/không mụn nước.

4. Điều trị ngứa lỗ tai trái
4.1. Mức độ nhẹ
Mức độ nhẹ được đặc trưng bởi ngứa và khó chịu nhẹ. Các chế phẩm bôi ngoài da không kháng sinh có kết hợp với corticosteroids được ưu tiên sử dụng. Các chế phẩm này nên được điều trị 3-4 lần/ngày và dùng trong vòng 7 ngày. Nếu triệu chứng ngứa lỗ tai trái đã được cải thiện, có thể cân nhắc ngưng sử dụng.

4.2. Mức độ trung bình
Mức độ trung bình được đặc trưng bởi mức độ đau và ngứa trung bình, có thể có ù tai nhẹ. Chế phẩm bôi ngoài da có chứa kháng sinh kháng tụ cầu vàng, trực khuẩn mủ xanh và corticosteroids là những chế phẩm được ưu tiên. Ciprofloxacin-hydrocortisone hoặc neomycin-polymyxin B-hydrocortisone là những hoạt chất thường được sử dụng. Thuốc được dùng 3-4 lần/ngày trong vòng 7 ngày, trừ ciprofloxacin được sử dụng 2 lần/ngày.
Sử dụng thuốc trong trường hợp này cần có sự thăm khám và tư vấn của bác sĩ để tránh trường hợp lạm dụng thuốc, độc tính do thuốc gây nên.
4.3. Mức độ nặng
Mức độ nặng được đặc trưng bởi những cơn đau dữ dội, ban đỏ và phù nề, có thể có nổi hạch kèm sốt. Trong trường hợp này, kháng sinh tiêm truyền phối hợp với chế phẩm bôi tại chỗ nên được sử dụng để quản lý tình trạng nhiễm trùng.
Nếu có các triệu chứng nghi ngờ viêm tai nặng, đừng chần chừ hãy đến cơ sở khám tai-mũi-họng gần nhất để được điều trị kịp thời.
5. Biện pháp phòng ngừa ngứa tai trái
5.1. Vệ sinh tai đúng cách
Làm sạch khuôn tai bên ngoài (bao gồm cả vành tai) là điều cần thiết. Việc loại bỏ ráy tai, da bong tróc sẽ giúp tai khô thoáng, ngăn cản sự phát triển của vi khuẩn.
Không nên dùng khăn tắm, ngón tay hoặc vật thể lạ đưa vào tai để làm sạch.
Ráy tai cũng là một hàng rào bảo vệ tai, việc làm sạch ráy tai sâu nên được thực hiện bởi người có chuyên môn và sử dụng dụng cụ nội soi làm sạch.
5.2. Biện pháp bảo vệ tai
Tai nên được tránh khỏi nước nếu có dấu hiệu viêm, ngứa lỗ tai. Trong trường hợp có tiếp xúc với nước, sử dụng nút bịt tai, lắc tai cho khô hoặc thổi khô tai (máy sấy ở mức độ nhiệt cách tai 30cm), sử dụng chế phẩm chứa cồn/axit acetic để làm khô tai.
Thiết bị trợ thính nên được tháo ra và làm sạch thường xuyên.
6. Lưu ý khi bị ngứa vành tai trái
Triệu chứng ngứa vành tai trái nếu chỉ xảy ra đơn độc rất có thể liên quan đến các bệnh lý về da, chủ yếu là viêm da tiếp xúc do hóa chất trong dầu gội, mỹ phẩm.
Trong một vài trường hợp, xỏ khuyên cũng là nguyên nhân gây ngứa vành tai, đặc biệt là những vị trí sụn tai. Người có da dễ bị kích ứng bởi các vật liệu kim loại nên lựa chọn khuyên tai phù hợp.
7. Khi nào cần đi khám và điều trị ngứa tai trái?
Ngứa tai trái là tình trạng mà hầu hết mọi người đều trải qua, chỉ khác nhau về mức độ cũng như là vị trí ngứa. Cần đánh giá triệu chứng ngứa tai trái cẩn thận dựa trên các dấu hiệu kèm theo như: ban đỏ, rỉ dịch, phù, ù tai trái,… cũng như bệnh sử của bản thân.
Một vài can thiệp nếu ngứa do các nguyên nhân cụ thể như: viêm da do hóa chất – ngưng sử dụng các sản phẩm phẩm chứa các hóa chất đó; bệnh vẩy nến – vệ sinh và điều trị bởi chuyên khoa da liễu; viêm tai do bơi lội – tạm ngưng tiếp xúc với nước hoặc bảo vệ tai khi tiếp xúc với nước;…

Trong trường hợp không xác định được nguyên nhân hoặc tình trạng ngứa tai ngày càng trở nặng, hãy đi khám bác sĩ để được điều trị kịp thời.
8. Câu hỏi thường gặp
Lỗ tai bị ngứa phải làm sao?
Cách trị ngứa tai trái tại nhà
– Sấy khô tai sau mỗi lần đi tắm.
– Sử dụng các loại cây trị ngứa dân gian: mướp đắng, đinh lăng, lá khế,…
Trẻ bị ngứa tai trái làm sao?
– Không để lỗ tai bé quá khô
– Vệ sinh, lấy ráy tai cho bé đúng cách
– Tiêm phòng cho bé đầy đủ
– Tránh tiếp xúc với môi trường khói bụi, thuốc lá
Ngứa tai trái báo hiệu điều gì?
Cảm giác ngứa tai như thế nào?






